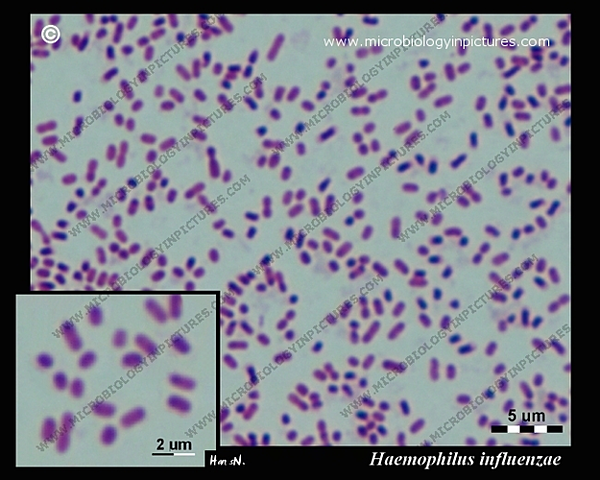
"Haemophilus influenzae"

-
las enfermedades contagiosas se deben a “gérmenes vivos” que pasan de diversas maneras de un individuo a otro. Girolamo Frascatoro (1546)
-
Describió protozoos (como Giardia, que encontró en sus propias heces), la estructura estriada del músculo, la circulación capilar, a descubrir los espermatozoides y los glóbulos rojos (por lo que también se le considera el fundador de la Histología animal), así como a detallar diversos aspectos estructurales de las semillas y embriones de plantas. Antonie van Leewenhoek
-
Descubrió la estructura celular de las plantas,acuñando el término célula. Robert Hooke (1635-1703)
-
Robert Hooke (1635-1703) usando microscopios compuestos, describió los hongos filamentosos.
-
"Omne vivum ex ovo” (todo ser vivo viene de otro ser vivo).
Francesco Redi (1621-1697).
Comprobar que los insectos y nematodos procedían de huevos puestos por animales adultos de su misma especie. -
En 1675 descubrió que en una gota de agua de estanque pululaba una asombrosa variedad de pequeñas criaturas a las que denominó “animálculos”. Antonie van Leeuwenhoek
-
Eduard Jenner, que mostró que la inoculación de una variedad similar de la viruela, que está presente en las vacas, podría protegernos contra la enfermedad.
se desarrolla la vacuna contra la viruela humana -
la teoría de la generación espontánea es
una falacia, postulando la ley de la biogénesis, que establece que todo ser vivo proviene de otro ser vivo ya
existente. Louis Pasteur (1861) -
Descubre el DNA en el esperma de la trucha.Aisló varias moléculas ricas en fosfatos, a las cuales llamó nucleínas (actualmente ácidos nucleicos), a partir del núcleo de los glóbulos blancos en 1869, y así preparó el camino para su identificación como los portadores de la información hereditaria, el ADN.
-
Aunque te suene a otra cosa, se refiere a Mycobacterium tuberculosis, la bacteria con forma de bacilo que descubrió Robert Koch en 1882.
-
Se utiliza tanto para poder referirse a la morfología celular bacteriana, como para poder realizar una primera aproximación a la diferenciación bacteriana, considerándose bacterias grampositivas a las que se visualizan de color morado. Christian Gram (1853-1938)
-
https//es.wikipedia.org/wiki/Postulados_de_Koch
-
Después de ensayos coronados exitosamente contra enfermedades animales, como el cólera de las gallinas, en 1885 aplica su tratamiento al joven Joseph Meister, quien había estado expuesto al virus de la rabia, y lo salva. Sólo en los 15 meses siguientes más de 2.500 víctimas de mordeduras de perros rabiosos fueron tratadas de la misma manera.
-
Recibió su doctorado en medicina en 1881. Inicialmente se dedicó al estudio de la bacteriología descubriendo la Escherichia coli en 1885.Este bacilo fue incluido, dentro del género de las bacterias, en la familia de las enterobacterias.
-
En 1887 Petri, un ayudante de Koch, sustituyó las engorrosas bandejas de vidrio cubiertas con campanas, usadas hasta entonces para los cultivos sólidos, por un sistema manejable de placas de cristal planas, que se conoce como cajas de Petri.
-
Serguei Winogradsky el primero en aislar una bacteria capaz de fijar nitrógeno atmosférico (Clostridium pasteurianum) y en explicar el ciclo del nitrógeno en la naturaleza (1890), siendo el holandés Martinus Beijerinck (1851-1931) el descubridor de Azotobacter como bacteria aerobia fijadora de vida libre (1901)
-
Paul Ehrlich en la que formula una explicación de la formación y especificidad de los anticuerpos, estableciendo una base química para la interacción de éstos con los antígenos.
-
Bordet desarrolló, en 1901, el primer sistema diagnóstico para la detección de anticuerpos, basado en la fijación del complemento, y que inició una larga andadura, que llega a nuestros días.
-
Almorth Wrigth y Stewart R. Douglas quienes descubren las opsoninas, anticuerpos presentes en los sueros de animales inmunizados y que, tras unirse a la superficie bacteriana, incrementan la capacidad fagocítica de los leucocitos.
-
Walter Reed, M. D., (1851 -1902) fue un médico del ejército de los Estados Unidos que en 1900 dirigió el equipo que confirmó la teoría (expuesta por primera vez en 1881 por el doctor/científico cubano Carlos Finlay) que la fiebre amarilla se transmite por mosquitos, en vez de por contacto directto
-
Paul Ehrlich descubrió la arsfenamina (conocida entonces con el nombre de Salvarsan), el primer tratamiento medicinal eficaz contra la sífilis, iniciando y dando nombre al concepto de quimioterapia.
-
En 1923, David Bergey, catedrático de bacteriología en la Universidad de Pennsylvania, y cuatro colaboradores más, publicaron un manual sobre características de las bacterias de interés médico conocidas hasta entonces, que podía utilizarse para la identificación bacteriana.
-
Fleming observó más tarde las placas y comprobó que las colonias bacterianas que se encontraban alrededor del hongo (más tarde identificado como Penicillium notatum) eran transparentes debido a una lisis bacteriana. Para ser más exactos, Penicillium es un moho que produce una sustancia natural con efectos antibacterianos: la penicilina.
-
Zacharías Janssen (1580-1638) inventó un microscopio con una especie de tubo con lentes en sus extremos, de 8 cm de largo soportado por tres delfines de bronce; Estos primeros microscopios aumentaban la imagen 200 veces.
-
Helmut Ruska inventa el microscopio electrónico.
-
Gerhard Domagk descubre las sulfamidas, el primer agente quimioterapeútico. Se emplean como antibióticos, antiparasitarios y coccidiostáticos en el tratamiento de enfermedades infecciosas.
-
Albert Schatz aisla la estreptomicina de un cultivo de Streptomyces griseus. Su jefe, Selman Waksman se apodera del descubrimiento y gana el premio Nobel de Medicina en 1952.https://es.wikipedia.org/wiki/Selman_Abraham_Waksman
-
Oswald Avery, Collin MacLeod y Maclyn McCarty demuestran que el DNA es el material genético.
-
Hershey y Chase estudiaron bacteriófagos, virus que atacan bacterias. Los fagos que utilizaban eran simples partículas compuestas de proteína y ADN, con sus estructuras externas hechas de proteínas y el núcleo interno compuesto por ADN.
-
James Watson y Francis Crick, a partir de estudios cristalográficos realizados por Wilkins y Franklin que sugerían que la molécula de ADN poseía una estructura helicoidal e inspirándose en las observaciones de otros investigadores – según las cuales los distintos ADN examinados presentaban siempre un número de adeninas igual al de timinas y un número de citosinas igual al de guaninas –, propusieron asignar una estructura de doble hélice a la molécula de ADN
-
Robert W. Holley aisla los RNAt, moléculas que incorporan los aminoácidos activados en las proteínas
-
Werner Arber, Daniel Nathans y Hamilton Smith descubren las enximas de restricción, herramientas esenciales para el desarrollo de la Ingeniería Genética.
-
Enfermedad de los legionarios.
En Filadelfia (Estados Unidos) aparece la enfermedad de los legionarios.
Generalmente se adquiere por respirar vapor de agua que contiene bacterias. El vapor puede provenir de bañeras o duchas calientes o de unidades de aire acondicionado en edificios grandes. Las bacterias no pasan de una persona a otra. -
as bacterias Escherichia coli en miniatura para producir de forma separada las cadenas A y B de la insulina humana, introduciendo para ello los genes que las codifican en las bacterias mediante un vector (pBR322). Posteriormente se llevaba a cabo la purificación, plegamiento y unión in vitro de las cadenas, mediante la oxidación de las cisteínas para formar los puentes disulfuro de la proteína activa.
-
Se logró a través de un control focalizado en combinación mediante el cual se identificaban rápidamente nuevos casos de viruela, y se aplicaba la vacunación en anillo.
La Organización Mundial de la Salud declara la erradicación de la viruela. -
Robert gallo y Luc Montagnier llevan a cabo el aislamiento e identificación del virus del Sida.
-
Carl Woese y Gary Olsen , transformando un árbol filogenético basado en datos del ARNr, mostrando la separación de bacterias, arqueas y eucariontes.
-
Clements y Bullivant descubren Epulopisciun fishelsoni, la mayor célula procariota.
-
Craig Venter secuencia el genoma de la bacteria Haemophilus influenzae (patógeno oportunista).
-
-
Heide H. Schulz en 1999 descubre en la costa de Namibia,la bacteria gigante Thiomargarita namibiensis encontrada en los sedimentos oceánicos de la plataforma continental. Es la bacteria más grande conocida, con una longitud de hasta 750 μm (0,75 mm),[1] lo que la hace visible a simple vista.
-
Aparece en Asia la gripe aviar, producida por el subtipo H5N1 del virus Influenza A que puede transmitir al hombre.
-
Fundación del Proyecto Microbioma Humano, la locomotora de la investigación biomédica pública mundial.
-
En México aparece un brote de gripe porcina, posteriormente llamada gripe AH1N1 (17/03/2009).Según la OMS el primer enfermo registrado en el mundo fue un niño de 10 años de edad, quien enfermó el 30 de marzo de 2009 en San Diego, CA, Estados Unidos,3 que no había tenido ningún contacto con cerdos, y además no había tenido ningún antecedente de haber viajado a México.
-
Se desarrolla un nuevo antibiótico a partir de la bacteria Eleftheria terrae ; la teixobactina , un antibiótico que ataca a un tipo de bacterias llamado Gram positivo.
-
Slava Epstein y suscolaboradores desarrollados un “ichip” (chip de aislamiento, cápsula de aislamiento), de plástico, que permite masificar el proceso parael cultivo de bacterias.
-
La OMS anuncia las 12 familias de bacterias resistentes a los antibióticos que representan las mayores amenazas de salud.
Plan projects on a visual timeline
Map milestones, phases, deadlines, and key events in one place so the sequence is easier to see and share. Timetoast is a timeline maker for work, school, research, and stories.